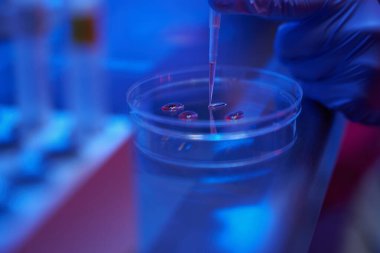
Koruyucu eldivenli adam, mikro manipülatör seti kullanarak petri kabında bir biyomateryalle çalışıyor.

Modern bir laboratuvarda embriyoların veya yumurtaların korunması için küçük pipetler kullanılıyor.
İhlal Bildirim Formu
Özel Boyut
(6812 x 4541, jpg)
Geniş Lisanslama
(6812 x 4541, jpg)
* Kurumsal aylık abonelikte çok avantajlı fiyatlar için tıklayın.
* Fiyatlara Kdv dahil değildir.
Örnek Kullanımlar: Web siteleri; reklam afişleri; ekran koruyucuları; sunumlar (PowerPoint, Flash, vs); filmler, videolar veya televizyon reklamları, gazete ve dergilerdeki reklamlar, bastırılmış reklam materyalleri; kitaplar için kapak, iş kartları; el ilanları; posterler; CD/DVD kapakları, etiketler veya ürün paketleri, kırtasiye, dosya, defterler, tükenmez kalem, kalemler, yapıştırmalar; takvimler; fincanlar veya bardaklar; fare altlığı; tişörtler, kıyafet vs. Detaylı Tablo için Tıklayınız!
En Çok Aranan Kelimeler
donanımSağlıkTıbbiprosedürteknolojiAygıtEmbriyoörnekLaboratuvarBilimKeşifYenilikŞırıngaişyeriGenetikÇalışma kıyafetleristerilBiyoteknolojiDondurucuDöllenmeAraştırmacıhazırlaryumurtakullanırembriyolojispermlerPetri Çanağıembriyologmanipülasyonsıvı azotbiomaterialModern ekipmanlarVitrifiyecryostorageLaboratuvar personeligüçlü mikroskopen uygun şartlarfertilization eggdelayed pregnancygrowing embryoscryo storage embryologyicsi procedurecryolaboratoryembryo biopsyesco incubatorsmall strawsBenzer İçerikler


Özel Boyut
(6812 x 4541, jpg)
Geniş Lisanslama
(6812 x 4541, jpg)
Eser Sahibi:
Tarih:
Warning: substr_count(): Empty substring in /home/lisansio/public_html/wp-content/themes/telifport_v3/inc-frontend/modal-urun-bilgileri.php on line 288